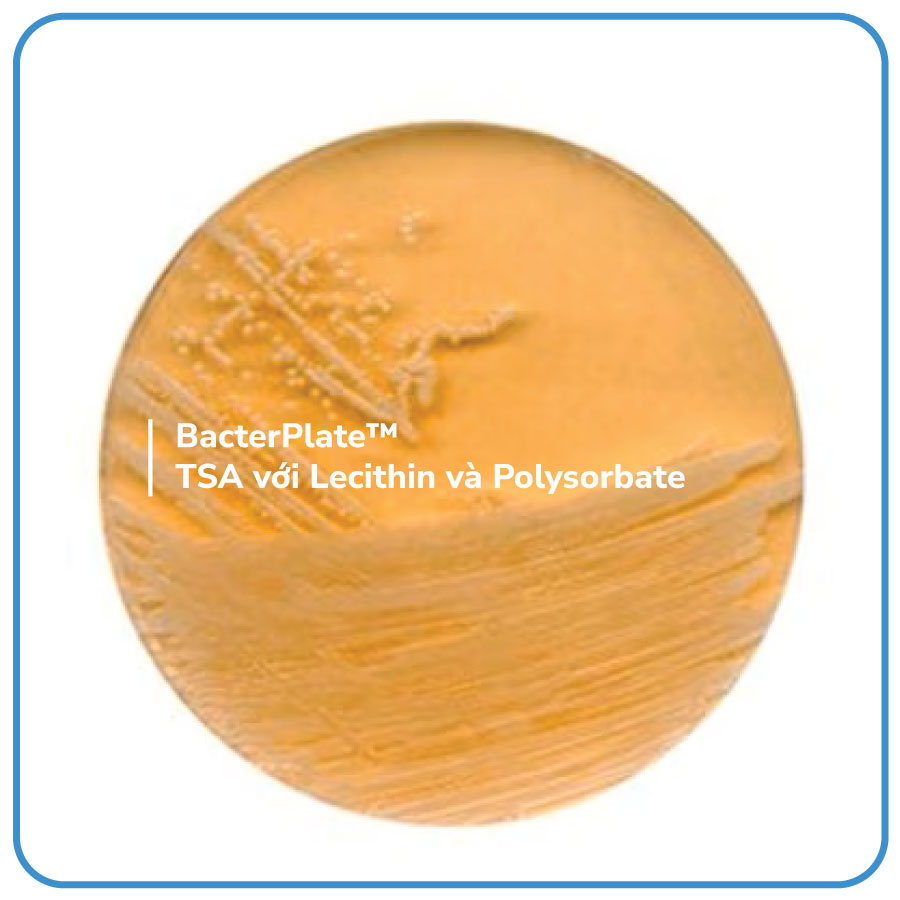

BacterPlate™ TSA với Lecithin và Polysorbate
Mã: 4102035
Mã đặt hàng/sản phẩm: 4102035
Số lượng tối thiểu: 1
Không có mô tả
Danh sách đặt hàng

BacterPlate™ TSA với Lecithin và Polysorbate
Mã: 4102035
Đơn vị: Cái
| Tên sản phẩm | Hình ảnh | Mã đặt hàng/sản phẩm | Đơn vị tính | Số lượng | Chọn vào giỏ hàng |
|---|---|---|---|---|---|
| BacterPlate™ TSA với Lecithin và Polysorbate | | 4102035 | Cái |
